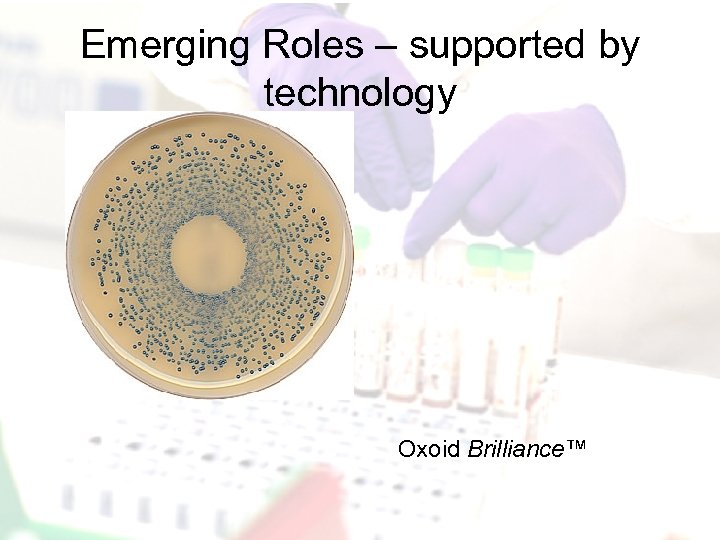
Emerging Roles – supported by technology Oxoid Brilliance™

6737c9f59f90c927cf5f63ed34652b6a.ppt
- Количество слайдов: 27

Re-profiling the Pathology Workforce British Society for Microbial Technology 24 th Annual Scientific Meeting Friday 8 th May 2009 Health Protection Agency, Colindale, London Alan. Tonge BSc CSci FIBMS, Manager and Professional Head for Pathology, University Hospital of North Staffordshire. Fellow, NHS Institute for Innovation and Improvement

Structure of Presentation • UHNS involvement in the Pathology Profiling Project • Restructuring Pathology at UHNS • Carter and DH Planning Tool

Pathology Profiling Project • CSO Skills for Health • UHNS, QEH Birmingham, Hereford • Reprofile the Pathology Workforce and after Lunch can you sort out World Hunger?

Background to ‘Re-profiling’ project • August 2006 – Initial Scoping Meeting UHB (Carter Report released 2 August 2006) • CSO funding from demise of Modernisation Agency (Arms Length Body Review) • Intro to NHS Improvement team via Anne Eason • Project funding used to employ project lead Zöe Smith on 12 month FT contract • Project Lead Jane Eminson nd

http: //www. dh. gov. uk/en/Publicationsandstatistics/Publications. Policy. And. Guidance/DH_4123205

What’s the problem? http: //www. wordle. net/

Kathleen Casey-Kirschling http: //www. foxnews. com/story/0, 2933, 301997, 00. html

Productivity Unit Labour Cost - the ratio of total labour cost to productive output Unit Labour Cost = Compensation Productivity Unit Labour Cost = Compensation Intensity X Efficiency Where: Intensity represents the proportion of work time focussing on the core work content, and efficiency represents the work output of a given amount of work effort.

Why is this useful? Skill Mix Unit Labour Cost = Compensation Intensity X Efficiency ‘Lean’ Technology

Saving Options • Reduce errors and remove waste • Reduce costs whilst maintaining safety and quality • Add value to the product or service through offering something new




Learning from the Pathology Profiling Project • Applying a systematic process has value • Competence based approach exposed gaps and identified areas for focus • Career Framework proved a difficult currency • Does a competence based approach value expert advice? • Are there sufficient roles for Associate Practitioners? • Can we be objective in analysing our own structures? • The breadth of the project resulted in a superficial report • The project avoided medical staffing and so did not fully explore the laboratory / medical interface

Workforce Changes at UHNS • Cost cutting (as opposed to Savings) • Not driven by Profiling project • Management restructuring in line with new (FFTF) model • Increase expectations on Band 6, 7, 8 a staff • Increased Band 3 and Band 2 posts • New Associate Practitioner posts

Associate Practitioners • New posts created • Technical and supervisory roles • Varying levels of laboratory experience and educational background • New educational routes – University Certificate in Biomedical Science – Foundation Degree in Biomedical Science
Emerging Roles – supported by technology Oxoid Brilliance™

• UF 100

Carter – Underlying Themes • Collinson Grant Healthcare – Phil Hudson – Managing Director – SBK • Masterclass in How to Model your Pathology Costs In-Depth Carter Methodology • True Costing for Pathology - Gain confidence in your costs: share best practice to drive forward your efficiency • Capacity Utilisation – Service Location – Logistics – Timeliness • Unit Labour Cost


PAT • Process • Activity • Task


etc…………….



http: //www. monash. edu. au/news/monashmemo/stories/20080409/slow-painting. html

Links • Modernising Scientific Careers http: //www. skillsforhealth. org. uk/js/uploaded/HCS/Sf. H%20 HCS%20 Report%20080404%20 Final. pdf • Pathology : towards a competence based workforce http: //www. dh. gov. uk/en/Publicationsandstatistics/Publications/Publi cations. Policy. And. Guidance/DH_084678 • Workforce planning tool http: //www. dh. gov. uk/en/Publicationsandstatistics/Publications/Publi cations. Policy. And. Guidance/DH_089905 • Christmas Tree Diagrams http: //www. skillsforhealth. org. uk/page/career-frameworks/service-redesign-tools • http: //www. economicsforeveryone. com • Wordle – Word Clouds http: //www. wordle. net/
6737c9f59f90c927cf5f63ed34652b6a.ppt